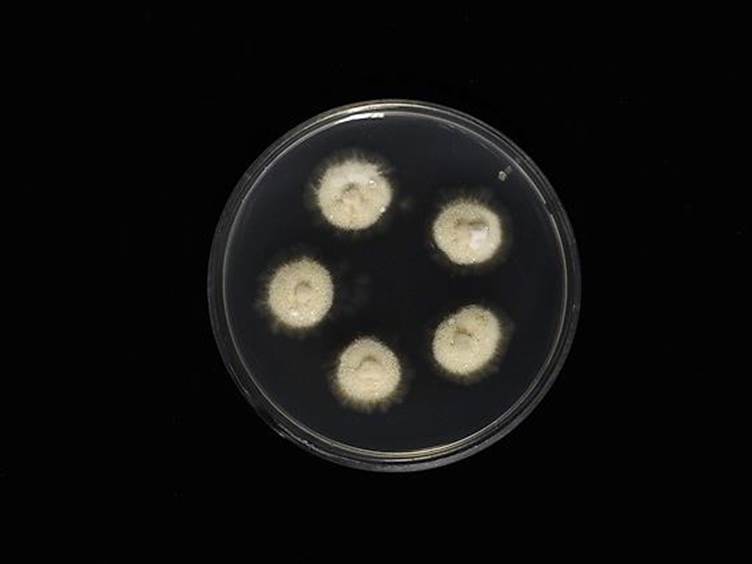

Holotype:
THAILAND, Nakhon Ratchasima Province, Khao Yai National Park, 8 Sep. 2015, K. Tasanathai, N. Kobmoo, W. Noisripoom, D. Thanakitpipattana, holotype BBH 40665, ex-type living culture TBRC 8095.
Habitat:
On twig and stems.
Host:
Lepidoptera larva.
Description:
 Stromata numerous, up to 20, simple, wiry to flexuous, 5-8 mm long, 1 mm wide on twig, unchanged in 3% KOH.
Stromata numerous, up to 20, simple, wiry to flexuous, 5-8 mm long, 1 mm wide on twig, unchanged in 3% KOH.  Perithecia superficial, loosely aggregated, covering lower part to apex of stroma, ordinal in arrangement, ovoid, brown-dark brown, 280-400 × 240-290 μm.
Perithecia superficial, loosely aggregated, covering lower part to apex of stroma, ordinal in arrangement, ovoid, brown-dark brown, 280-400 × 240-290 μm.  Asci hyaline, cylindrical, 8-spored, 150-190 × 5-8 μm. Ascospores hyaline, cylindrical to vermiform, remaining whole after discharge with distinct septation, 120-150 × 2-2.5 μm.
Asci hyaline, cylindrical, 8-spored, 150-190 × 5-8 μm. Ascospores hyaline, cylindrical to vermiform, remaining whole after discharge with distinct septation, 120-150 × 2-2.5 μm.
Culture characteristics:
Colonies on PDA growing very slowly, attaining a diam of 6 mm within 20 d at 20 °C. Colonies white to yellowish white, velvety to funiculose, colonies reverse greyish yellow to olive bearing conidiogenous cells and conidia of the Hirsutella asexual morph. Conidiogenous cells monophialidic, sometimes polyphialidic, with up to 2 lateral necks arising from hyphae laterally or terminally, hyaline, smooth, tapering gradually or abruptly into a short slender neck. Phialides 30–40 μm, phialide base 16–25 × 3–5 μm, phialide neck rough and warty, 10–20 × 1 μm. Conidia hyaline, 1-celled, smooth-walled, oval to lemon shaped, 5–6 × 3–4 μm, without a mucous sheath.
Colonies on PDA growing very slowly, attaining a diam of 6 mm within 20 d at 20 °C. Colonies white to yellowish white, velvety to funiculose, colonies reverse greyish yellow to olive bearing conidiogenous cells and conidia of the Hirsutella asexual morph. Conidiogenous cells monophialidic, sometimes polyphialidic, with up to 2 lateral necks arising from hyphae laterally or terminally, hyaline, smooth, tapering gradually or abruptly into a short slender neck. Phialides 30–40 μm, phialide base 16–25 × 3–5 μm, phialide neck rough and warty, 10–20 × 1 μm. Conidia hyaline, 1-celled, smooth-walled, oval to lemon shaped, 5–6 × 3–4 μm, without a mucous sheath.
Reference:
Luangsa-ard JJ, Tasanathai K, Thanakitpipattana D,et al. (2018). Novel and interesting Ophiocordyceps spp. (Ophiocordycipitaceae, Hypocreales) with superficial perithecia from Thailand. Studies in Mycology 89: 125–142.
DOI: https://doi.org/10.1016/j.simyco.2018.02.001Species |
Strain |
Compound |
Pubchem CID |
Biological activity |
Reference |
|---|
|
Strain |
LSU | RPB1 | RPB2 | TEF1 |
|---|---|---|---|---|
| TBRC 8094 | MF614647 | MF614664 | MF614678 | MF614631 |
| TBRC 8095 | MF614648 | MF614663 | MF614679 | MF614632 |